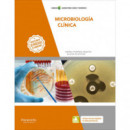
Microbiologã­a Clã­nica

Ver más grande
Ver más grande
¡Compra online miles de productos en Guanxe.com!
Entrega rápida desde 24/72 horas*. Ver condiciones.
Marcas 100% originales. Más info.
GUANXE ofrece a sus clientes la posibilidad de ejercer su derecho de devolución de cualquier artículo comprado en el plazo de 14 días naturales desde la fecha de recepción.
En dicho plazo aceptamos devoluciones siempre que el producto esté en óptimas condiciones y sin abrir, con su embalaje y precinto original (caja sin abrir), sin ningún tipo de uso y apto para la venta (excepto en moda y calzado que se podrá abrir el paquete para probar el producto en el domicilio). Los gastos de envío para la devolución correrán por cuenta del comprador, excepto si el artículo pertenece a la categoría de Ropa y Moda o Zapatos en cuyo caso la devolución es gratuita. Los cambios de tallas, modelos o colores no están permitidos, solo las devoluciones.
Las cajas originales de calzado deben ir empaquetadas con una bolsa para que no sufran daño. Las pegatinas de recogida de la mensajería no pueden pegarse directamente en la caja original sino en el envoltorio protector.
Los gastos de envío cuando corran a cuenta del comprador serán de 5,90 € si lo recoge GUANXE. Una vez recibida la mercancía, nuestro departamento de calidad la comprobará, si efectivamente está en perfectas condiciones, se procederá al abono del importe de los productos devueltos mediante la misma forma de pago utilizada en el pedido.
Guanxe dispondrá de 14 días que desde el conocimiento del desistimiento para el reembolso.
Importante: Le informamos que, tal y como establece el Real Decreto Legislativo 1/2007 del 16 de noviembre, por el que se aprueba el texto refundido de la Ley General para la Defensa de los Consumidores y Usuarios y otras leyes complementarias, no se aceptan, por motivos de higiene, las devoluciones de los productos relacionados con el Cuidado Personal, Ropa Interior, Salud, Higiene y Baño. Por ese mismo motivo el producto que desee devolver debe estar sin abrir, dentro de su embalaje y precinto original.
Envíos erróneos:
Si le ha llegado un producto diferente al que había pedido, contacte con nosotros en un plazo máximo de 72 horas siguientes a la recepción del pedido a través del formulario de contacto y gestionaremos su solicitud. Se realizará una previa comprobación del caso, el producto debe estar en óptimas condiciones, con su embalaje original, sin ningún tipo de uso y apto para la venta, también se realizarán unas comprobaciones internas.
Para agilizar el proceso rogamos nos envíe las siguientes fotografías de producto en cuestión adjunto en su solicitud:
- Fotografía de la parte delantera del producto en su embalaje original.
- Fotografía del código de barras (EAN) del producto.
En este caso, procederemos a la revisión de su solicitud y organizaremos la recogida del producto con usted.
En caso de un error de GUANXE en la preparación del pedido, los gastos de transporte para el cambio correrán a cuenta de nosotros, en caso de error del cliente en el momento de la compra, deberá abonar el cliente, el coste del servicio de transporte para el cambio. *No se admitirá la devolución, así como la
reclamación de un artículo faltante, si no ha sido comunicado dentro del plazo establecido.
Roturas o defectos de origen:
En el caso de que su pedido haya llegado defectuoso desde origen o a sufrido una rotura, contacte con nosotros a través de nuestro formulario de contacto en las 72 horas siguientes a la recepción y gestionaremos su incidencia.
Importante: No se admitirá la devolución de un artículo dañado, así como defectuoso de origen, si no ha sido comunicado dentro del plazo previamente establecido. En dichos casos, necesitaremos siempre una o varias pruebas del comprador para poder determinar los daños/defectos y poder realizar una correcta gestión de la incidencia. Deberán enviar fotografías de la mercancía/pedido o alguna otra prueba que nos permita determinar los hechos. Finalizado el proceso de comprobación, si procede, se enviará un mensajero para reponer o devolver la mercancía. En caso de recibir mercancía dañada o rota, le aconsejamos que también se lo haga saber a la agencia de transportes que haya gestionado la entrega de tu pedido. A pesar de nuestros esfuerzos, pueden surgir imprevistos o roturas de stock. En todo momento el cliente estará informado de estás contingencias y del plazo previsto de entrega con exactitud.
| Dimensiones Libro | 270 x 210 |
| Encuadernación Libro | Bolsillo |
| Idioma Libro | spa |
| Peso Libro | 780 |
| Páginas Libro | 285 |
| Autor Libro | Nerea |
| Editorial | S.A |
Por el momento no hay preguntas.